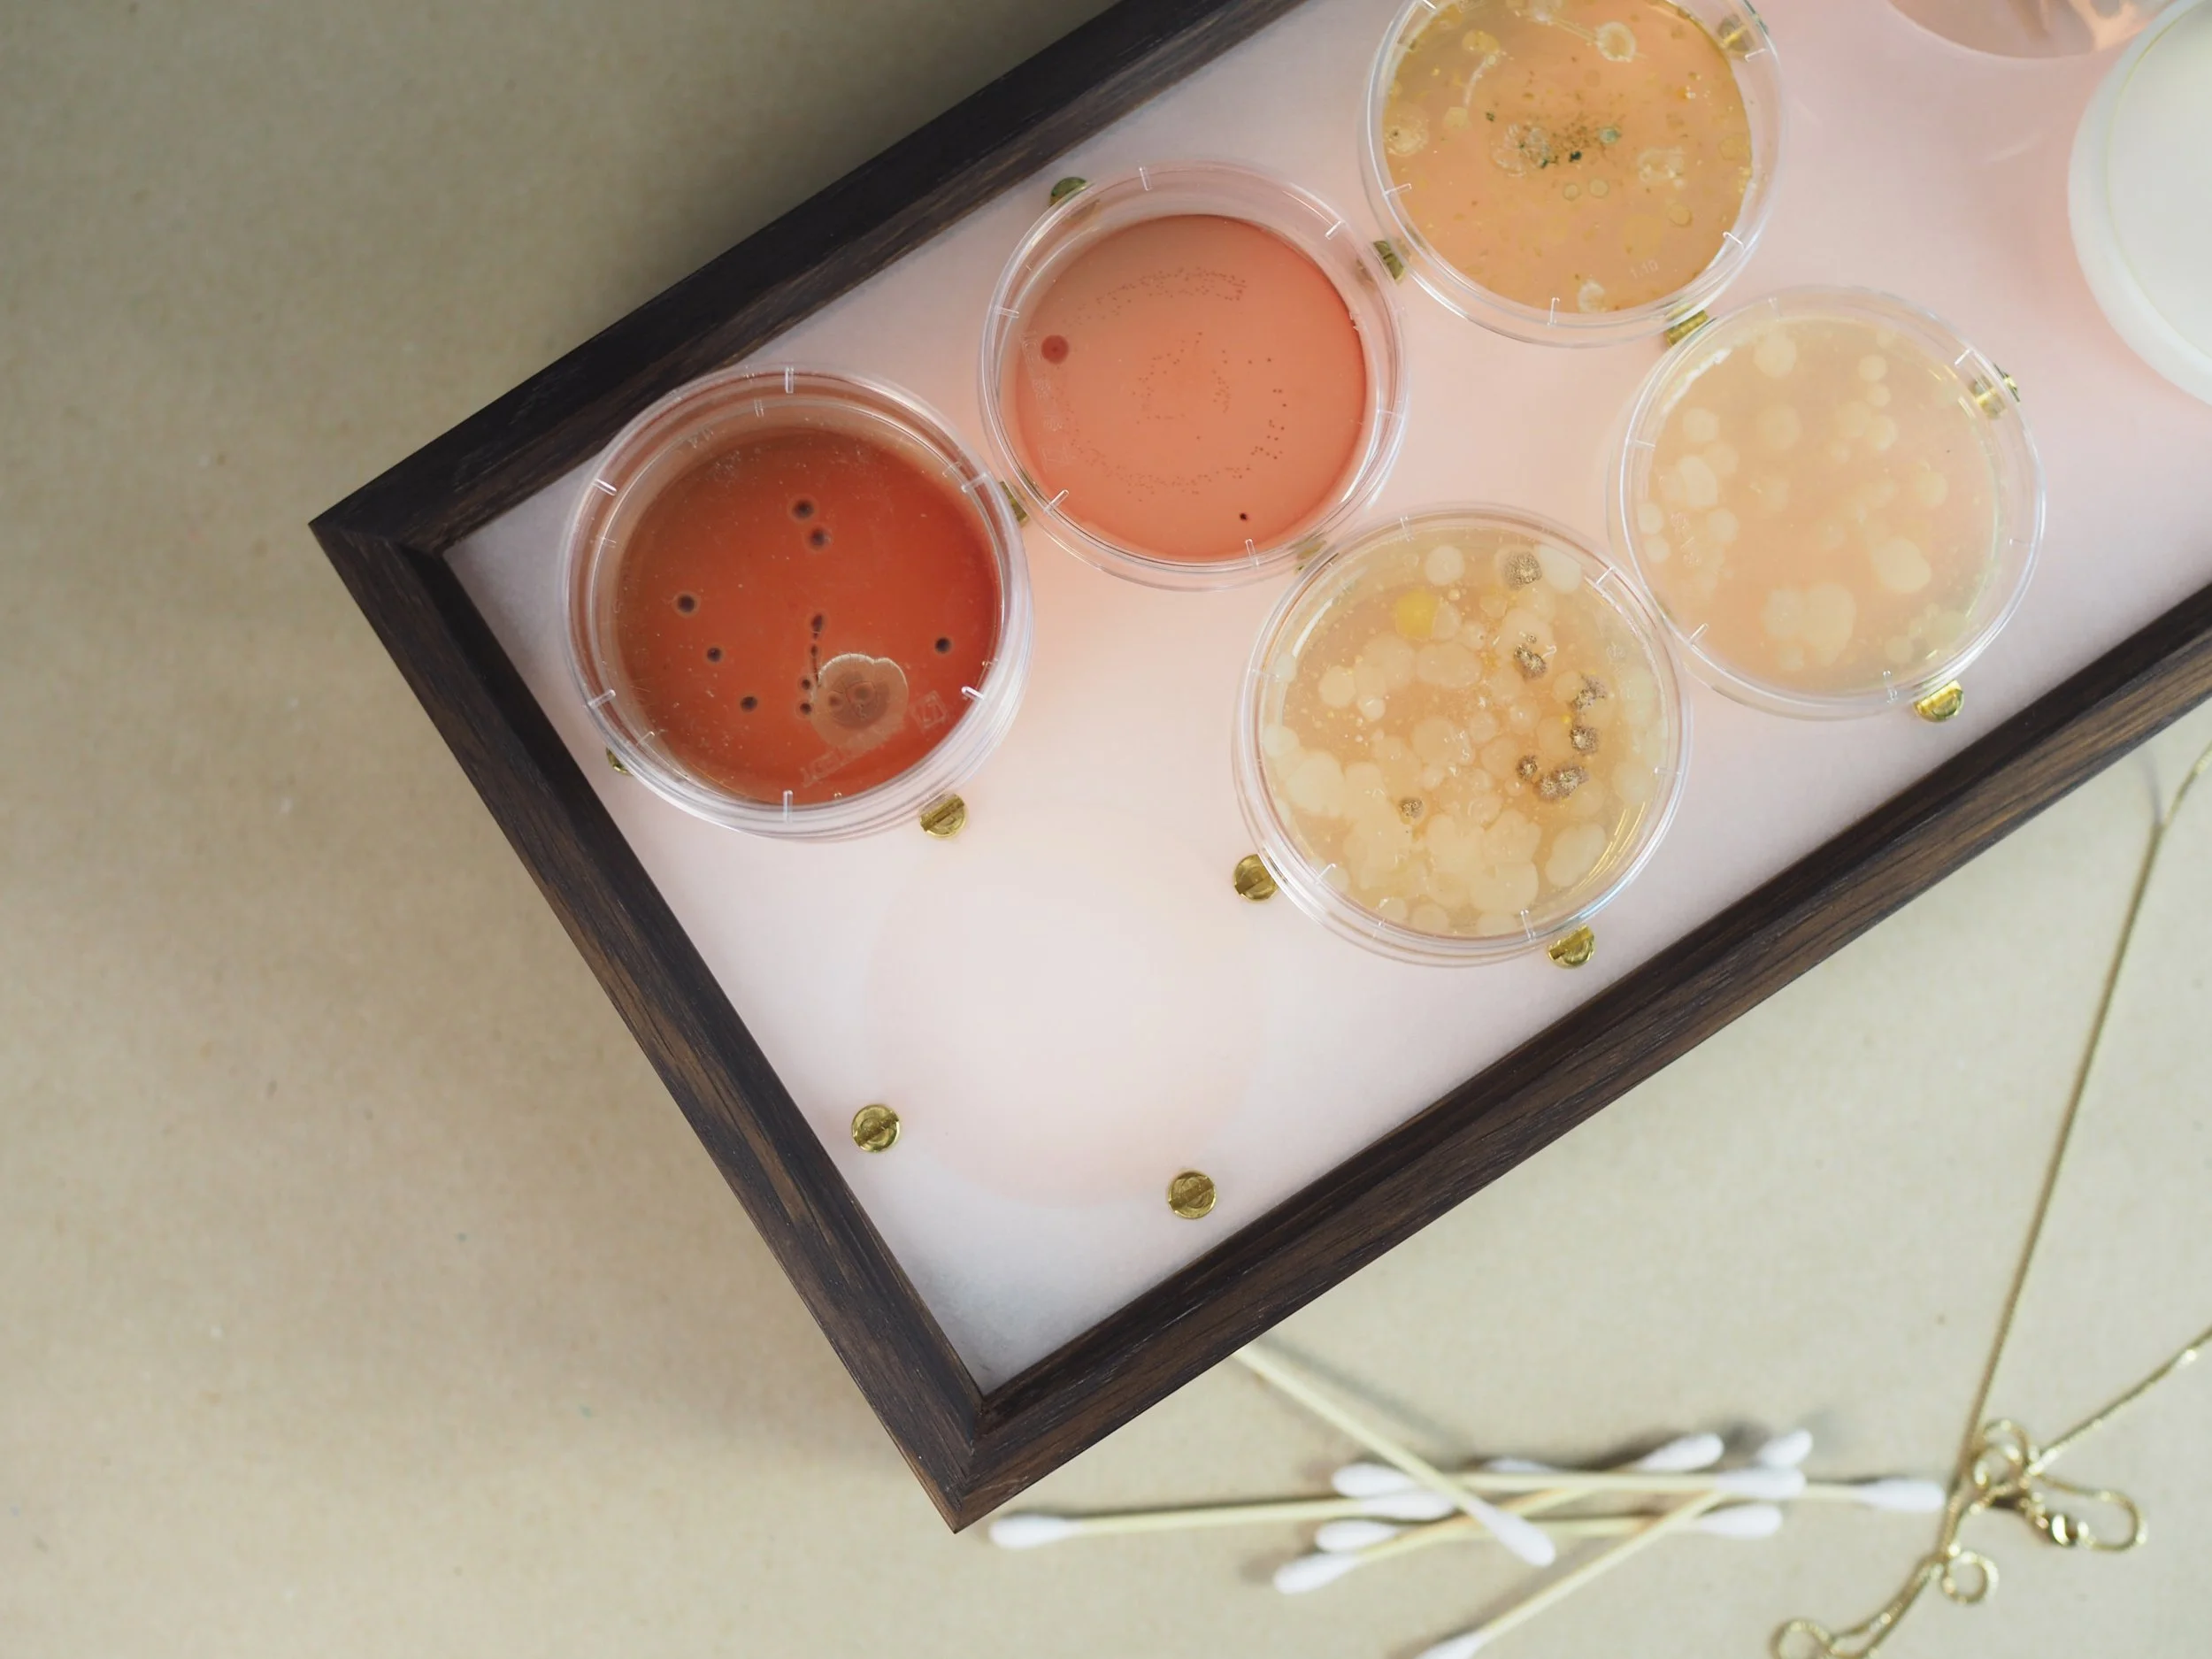

Gut Feeling
2019
In collaboration with the IxD lab, IT University of Copenhagen

2019
In collaboration with the IxD lab, IT University of Copenhagen